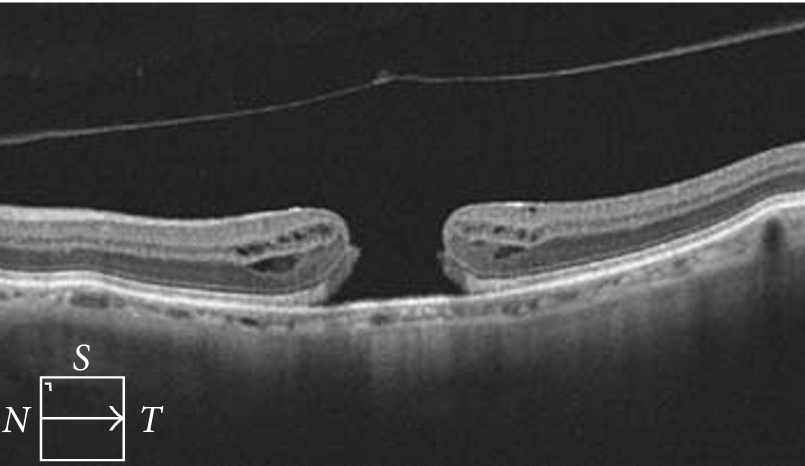
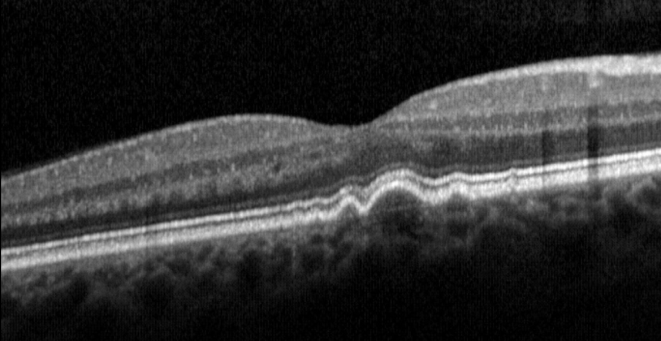

ОСТ — Это метод отображения структуры биологических тканей организма в поперечном срезе с высоким уровнем разрешения. Действие оптического когерентного томографа основано на принципе низкокогерентной интерферометрии, то есть, в ОСТ используется когерентный свет инфракрасного диапазона с длиной волны 820 нм.
Оптическая когерентная томография в офтальмологии — это бесконтактная технология, позволяющая исследовать структуру переднего и заднего отрезка глазного яблока в прижизненных условиях.
В настоящее время в офтальмологии без проведения оптической когерентной томографии невозможна полноценная диагностика всех заболеваний сетчатки, глаукомы. Кроме этого, ОСТ привносит значительное количество информации о состоянии переднего отрезка глаза при его дистрофических и воспалительных заболеваниях.
Для пациента процедура ОСТ проста и совершенно безболезненна. Специальной подготовки не требуется. Для улучшения качества снимков доктор может временно расширить пациенту зрачки, используя специальные глазные капли. Затем доктор просит пациента поставить подбородок на специальную площадку прибора и следить за фиксирующей меткой. Через несколько секунд обследование для пациента заканчивается. Доктор начинает анализировать снимки. Анализ снимков, их интерпретирование, распечатка и описание может занимать определенное время, но обычно не более нескольких минут.
Ниже представлены снимки, полученные при проведении ОСТ.
Как было описано выше, ОСТ позволяет получать снимки переднего и заднего отрезков глазного яблока.

Рисунок «Роговица»

Рисунок «Узкий угол передней камеры»

Рисунок «Нормальный профиль фовеа и отграниченная стрелками хориоидея»

Рисунок «Карта толщины сетчатки в макулярной области при диабетическом макулярном отеке»
Рисунок » Макулярное отверстие»
Рисунок » Друзы в макулярной области при сухой форме возрастной макулярной дегенерации сетчатки»

Рисунок «Отрыв пигментного эпителия в центральной области сетчатки при влажной форме возрастной макулярной дегенерации сетчатки»

Рисунок «Профиль экскавации диска зрительного нерва при глаукоме»

Рисунок «Толщина комплекса ганглиозных клеток и внутреннего плескиформного слоя в макулярной зоне в норме»

Рисунок «Толщина слоя нервных волокон в перипапиллярной области сетчатки при глаукоме»













































